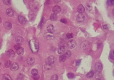

SYNCHRONOUS OCCURRENCE OF THREE DIFFERENT THYROID TUMORS
- PMID: 33363662
- PMCID: PMC7748223
- DOI: 10.4183/aeb.2020.366
SYNCHRONOUS OCCURRENCE OF THREE DIFFERENT THYROID TUMORS
Abstract
Background: Thyroid nodules are common; however, the association of two or more different tumors in the thyroid gland is unusual. We present a first case with the association of three histological types of thryroid tumors. To the best of our knowledge, this association has not been reported in the literature before. We aim here to highlight the possible coexistence of many lesions in the thyroid gland and to discuss treatment options.
Case presentation: We report the case of a female patient who presented with a multinodular goiter. The final pathology after total thyroidectomy found the association of a multifocal papillary thyroid microcarcinoma arising within a Hurthle cells adenoma in a lobe and a noninvasive follicular thyroid neoplasm with papillary nuclear features in the other lobe. Due to the very low risk of recurrence, the patient was not treated with radioactive iodine.
Conclusions: Many controversies remain about the management of Hurthle cells tumors and many variants of papillary thyroid carcinoma. Although the management of our case did not change, more studies are necessary to analyze the evolution of patients with multiple thyroid neoplasms. When discussing therapeutic options, the advantages and disadvantages should be considered case by case based on disease staging.
Keywords: Hurthle cell tumor; NIFPT; papillary cells carcinoma; thyroid gland.
©by Acta Endocrinologica Foundation.
Conflict of interest statement
The authors declare that they have no conflict of interest.
Figures

References
-
- Ono JC, Wilbur DC, Lee H, Yang J, Krane JF, Bongiovanni M, Faquin WC. Cytologic features of focal papillary thyroid carcinoma arising within follicular adenoma: a masked cytomorphologic analysis of 17 cases. Acta Cytol. 2011;55(6):531–538. - PubMed
-
- Rana C, Kumari N. Agarwal A, editor. Hurthle Cell Adenoma and Papillary Microcarcinoma in Thyroid: Collision Tumors. World J Endocr Surg. 2018;10(2):134–136.
-
- Lam AK. Pathology of Endocrine Tumors Update: World Health Organization New Classification 2017-Other Thyroid Tumors. 2017;22(4):209–216.
Publication types
LinkOut - more resources
Full Text Sources
